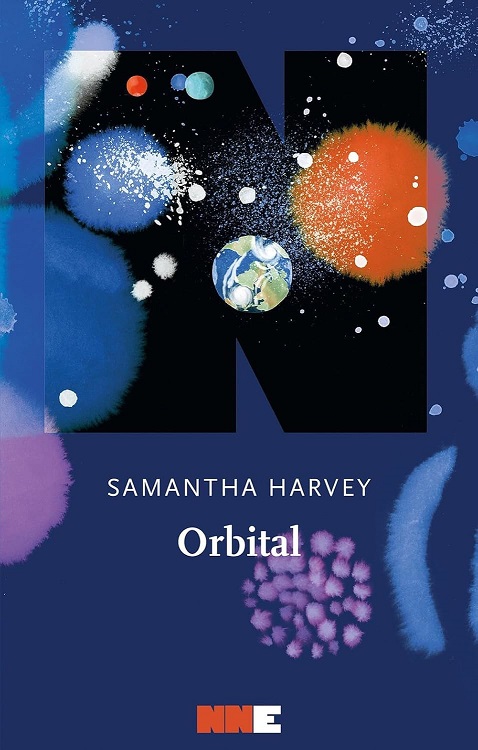

Ruotano intorno alla Terra nella stazione spaziale, così uniti e così soli che ogni tanto persino pensieri e mitologie si fondono. A volte sognano gli stessi sogni – frattali e sfere azzurre e volti familiari inghiottiti dall’oscurità, e il nero vivace dello spazio che è una frustata a tutti i sensi. Lo spazio puro è una pantera, selvatica e primordiale; la sognano aggirarsi ferale tra loro.
La recensione di Orbital, Samantha Harvey
Quattro astronauti di nazionalità diversa – americana, giapponese, inglese e italiana – e due cosmonauti russi sono in missione sulla Stazione Spaziale Internazionale per nove mesi. Il romanzo segue una giornata sulla Stazione, precisamente un martedì, ventiquattro ore lungo sedici orbite terrestri diurne nell’emisfero settentrionale. Ventiquattro ore da misurare con il tempo terrestre così da mantenere la mente salda e non perdersi tra albe e tramonti, notti e giorni, corpi sempre più lenti.
Cosa pensano gli astronauti mentre a quattrocento chilometri sotto di loro la Terra gira velocemente?
È una vita fatta di lavori quotidiani sempre uguali: esami di ruotine da ripetere a fine giornata, mangiare, dormire, fare ginnastica. Il tempo si dilata a bordo della Stazione e gli occhi seguono costantemente lo spettacolo mai uguale della Terra da fotografare e documentare. C’è un uragano potente che si muove e si rafforza, la notte è illuminata da centinaia di fulmini e a Nord l’aurora boreale regala cortine da brividi in mezzo a cui passare.
La mia opinione su Orbital, Samantha Harvey
Orbital è il romanzo vincitore del Booker Prize 2024 ed è un libro molto particolare. Samantha Harvey scrive una storia che può sembrare statica eppure c’è il lutto, la nostalgia, il matrimonio in crisi, la religione o l’assenza di essa. Ogni personaggio emerge in un dialogo costante con la Terra e con sé stesso.
La Terra è protagonista assoluta, luogo a cui gli astronauti non vedono l’ora di tornare ma che hanno sempre desiderato guardare dallo spazio. La Terra è casa e madre, voce che risuona più forte e riconoscibile tra tutte le voci dell’Universo. È stupefacente, una distesa di colori, luci e oscurità, un luogo che nella distanza diventa ancora più bello e desiderabile.
Orbital è un libro di pensieri e descrizioni. L’autrice dipinge immagini vividissime dello Spazio e la Terra vista dalla Stazione Spaziale è una tela intessuta di mille trame, ove sottili ove spesse, di ricami, di colori gettati o distribuiti pazientemente, di pianure e increspature. E intorno ad essa la notte e il giorno si rincorrono, la Luna, lontana e ancora più affascinante fa capolino- oh, beati gli astronauti dell’altra missione che stanno per allunare, cosa importa della Stazione Spaziale se si può di nuovo andare sulla Luna – e in mezzo a tutte queste albe e tramonti, lungo le orbite su cui ci muoviamo insieme agli astronauti come un corpo unico, ormai anche il lettore se chiude gli occhi sogna lo spazio, il tempo si dilata e Orbital da libro breve diventa infinito.
La Terra sfreccia sotto di noi, ci commuoviamo davanti alla pura bellezza del nostro pianeta e non importa se siamo soli o se tra migliaia di anni qualcuno coglierà i segnali inviati, ciò che importa è guardarla, ascoltare il suo canto selvaggio ed esplosivo che risuona dentro di noi, immortale e viscerale.
Buona lettura.
Orbital
Samantha Harvey
NN Editore, 2025, p. 176, €. 18,00








